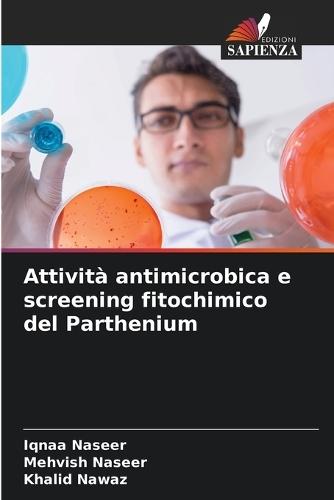
Attività antimicrobica e screening fitochimico del Parthenium

Staff Picks
Biography
Middle-Grade Fiction
Australian Non-Fiction
Australian Fiction
Fiction
Lifestyle
Art
Young Adult
Cooking
Non-Fiction
Language & Linguistics
Fiction
Reference, Information & Interdisciplinary Subjects
Humanities
Society & Social Sciences
Economics, Finance, Business & Management
Law
Medicine
New and Notables
Mathematics & Sciences
Earth Sciences, Geography, Environment & Planning
Lewis
Ruby
Technology, Engineering & Agriculture
Computing & Information Technology
Health & Personal Development
Lifestyle, Cookery, Sport, Hobbies, Craft & Pets
Children's, Young Adult & Educational

Free Delivery Over $100